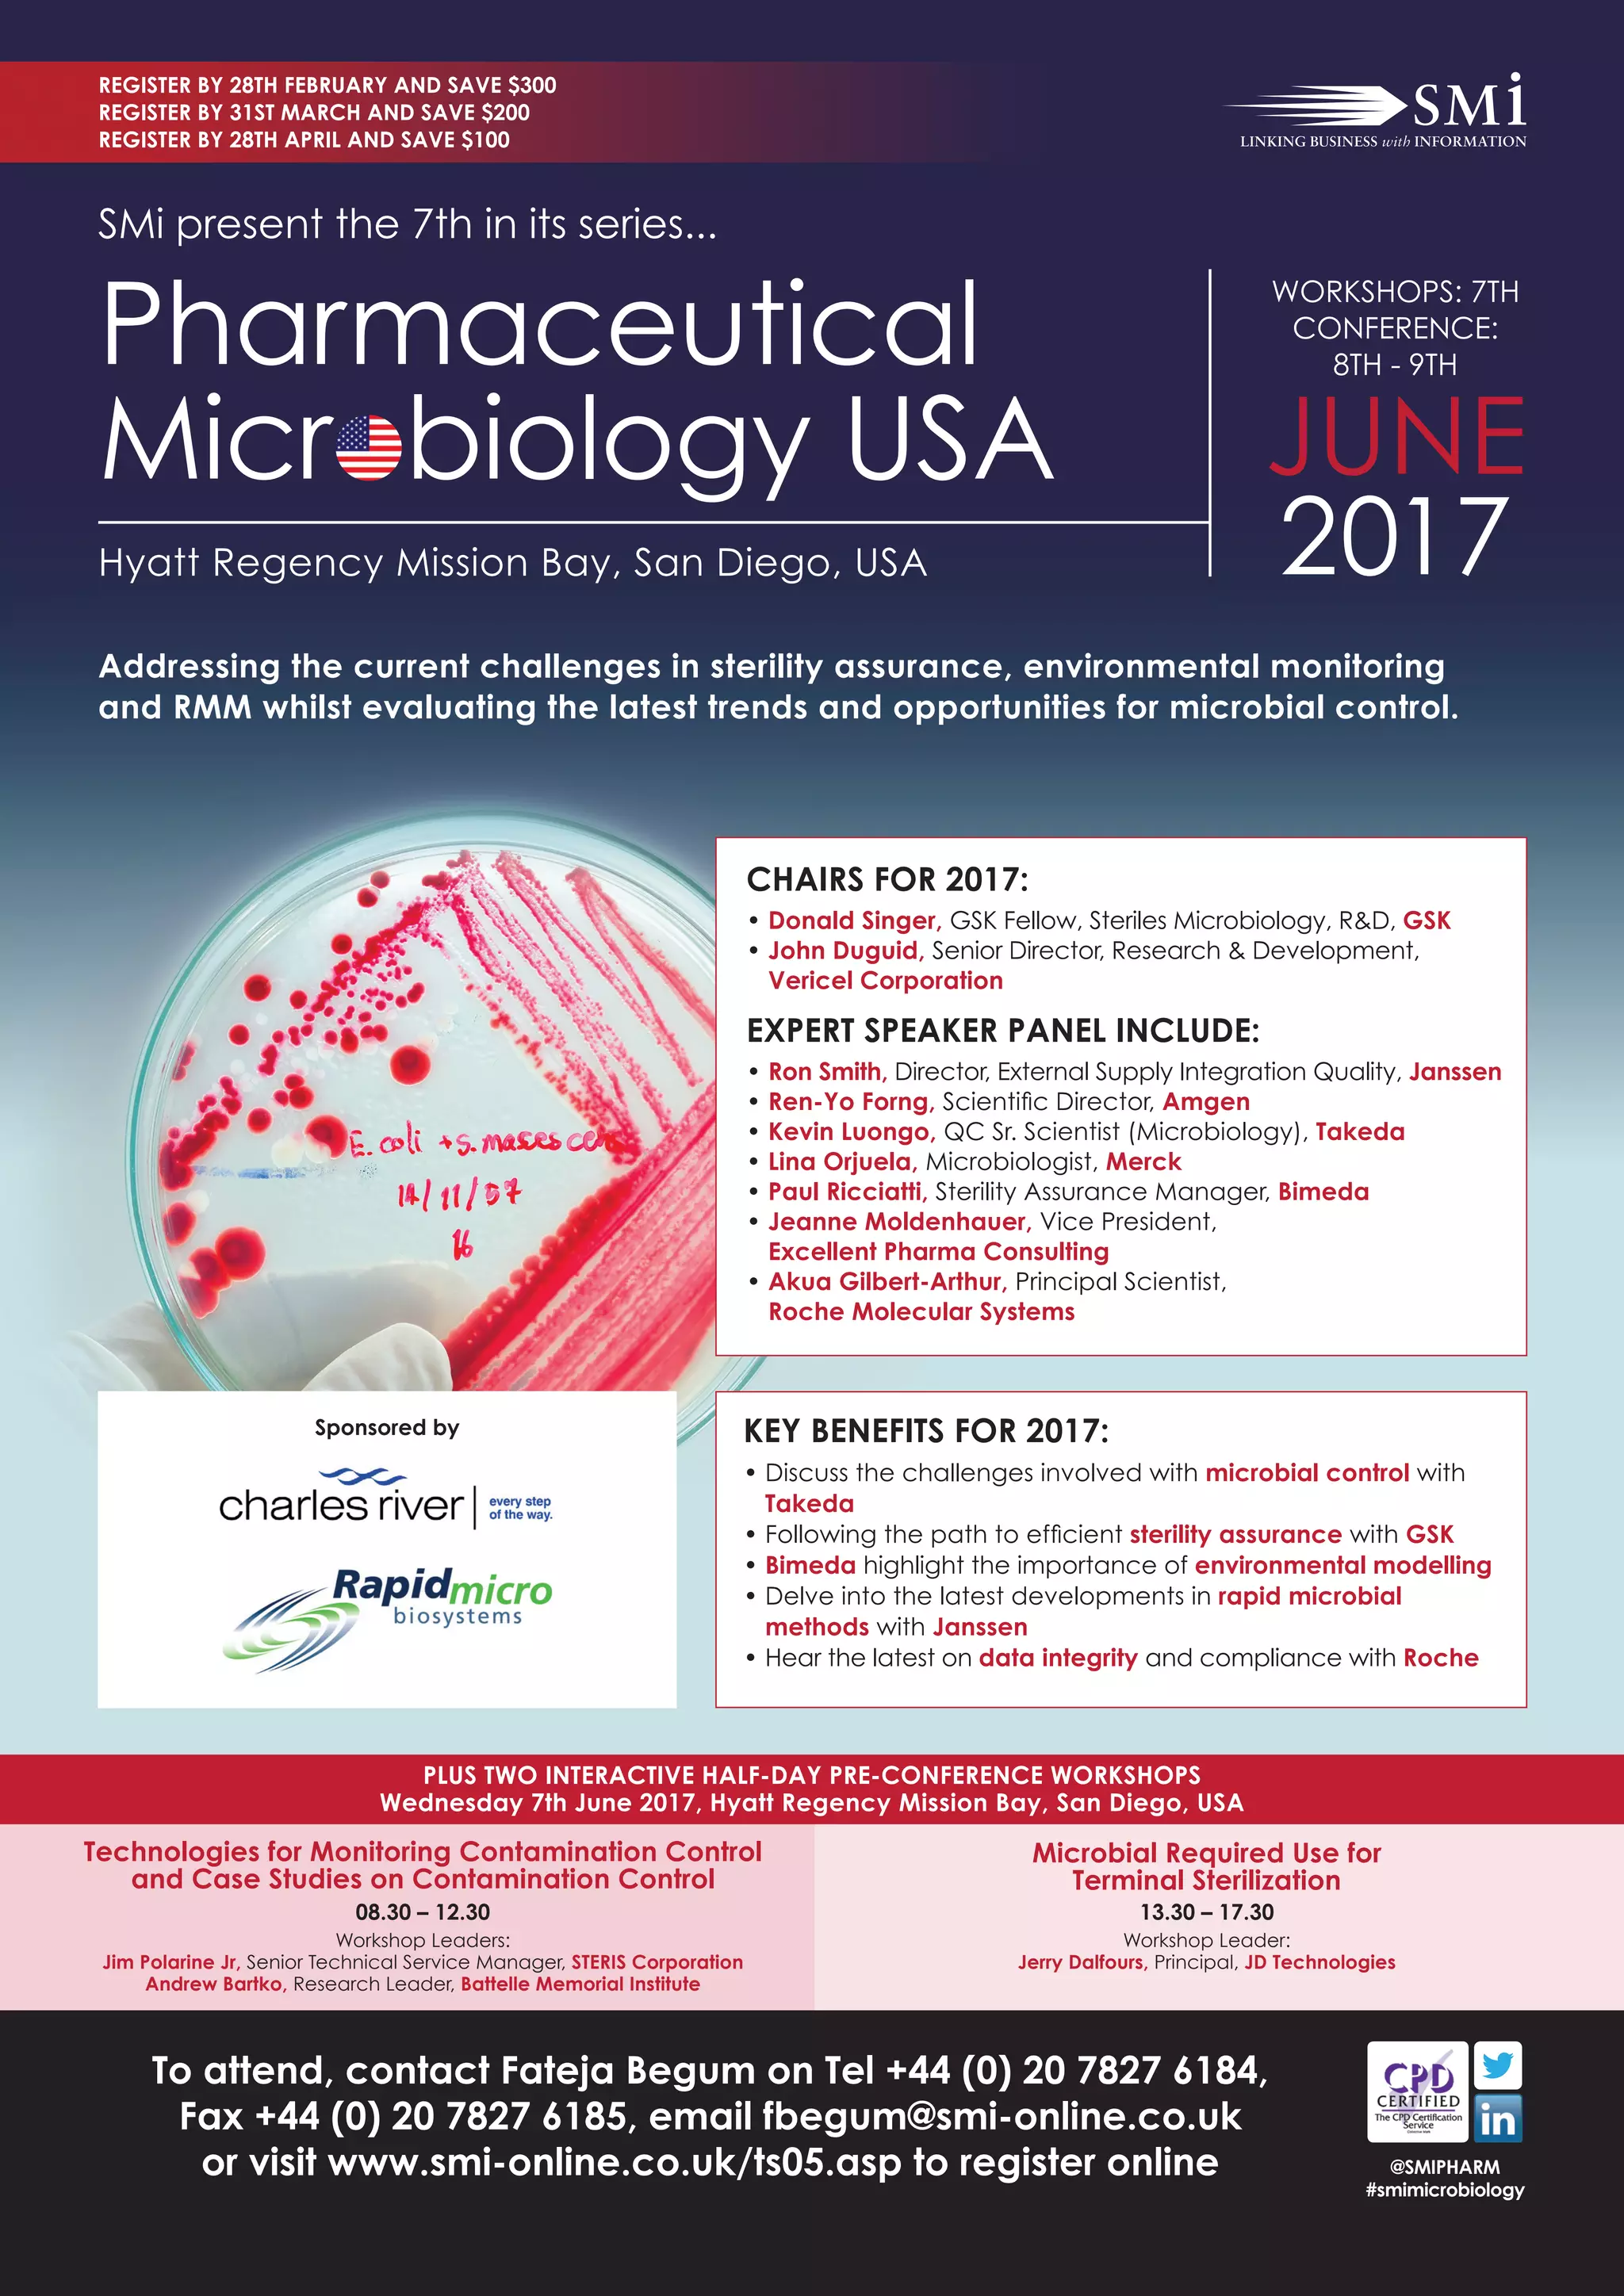
Pharmaceutical Microbiology USA 2017 PDF

2016-2017 Microbiology Catalog Uf
2016-2017 Microbiology Catalog Uf - A good designer knows that printer ink is a precious resource. The website "theme," a concept familiar to anyone who has used a platform like WordPress, Shopify, or Squarespace, is the direct digital descendant of the print catalog template. This well-documented phenomenon reveals that people remember information presented in pictorial form far more effectively than information presented as text alone. Only connect the jumper cables as shown in the detailed diagrams in this manual. The template represented everything I thought I was trying to escape: conformity, repetition, and a soulless, cookie-cutter approach to design. A parent seeks an activity for a rainy afternoon, a student needs a tool to organize their study schedule, or a family wants to plan their weekly meals more effectively. This is a revolutionary concept. Teachers use them to create engaging lesson materials, worksheets, and visual aids. The choice of a typeface can communicate tradition and authority or modernity and rebellion. Instead, it is shown in fully realized, fully accessorized room settings—the "environmental shot. 46 The use of a colorful and engaging chart can capture a student's attention and simplify abstract concepts, thereby improving comprehension and long-term retention. The print catalog was a one-to-many medium. My toolbox was growing, and with it, my ability to tell more nuanced and sophisticated stories with data. The template has become a dynamic, probabilistic framework, a set of potential layouts that are personalized in real-time based on your past behavior. The first real breakthrough in my understanding was the realization that data visualization is a language. Furthermore, the concept of the "Endowed Progress Effect" shows that people are more motivated to work towards a goal if they feel they have already made some progress. 41 Different business structures call for different types of org charts, from a traditional hierarchical chart for top-down companies to a divisional chart for businesses organized by product lines, or a flat chart for smaller startups, showcasing the adaptability of this essential business chart. The utility of a printable chart in wellness is not limited to exercise. Your safety and the safety of your passengers are always the top priority. 22 This shared visual reference provided by the chart facilitates collaborative problem-solving, allowing teams to pinpoint areas of inefficiency and collectively design a more streamlined future-state process. The main spindle is driven by a 30-kilowatt, liquid-cooled vector drive motor, providing a variable speed range from 50 to 3,500 revolutions per minute. This artistic exploration challenges the boundaries of what a chart can be, reminding us that the visual representation of data can engage not only our intellect, but also our emotions and our sense of wonder. 3 A printable chart directly capitalizes on this biological predisposition by converting dense data, abstract goals, or lengthy task lists into a format that the brain can rapidly comprehend and retain. Paper craft templates are sold for creating 3D objects. It is a tool for learning, a source of fresh ingredients, and a beautiful addition to your home decor. A professional, however, learns to decouple their sense of self-worth from their work. 33 For cardiovascular exercises, the chart would track metrics like distance, duration, and intensity level. Everything is a remix, a reinterpretation of what has come before. Every element on the chart should serve this central purpose. Journaling is an age-old practice that has evolved through centuries, adapting to the needs and circumstances of different generations. The pairing process is swift and should not take more than a few minutes. It’s a form of mindfulness, I suppose. They are easily opened and printed by almost everyone. A truncated axis, one that does not start at zero, can dramatically exaggerate differences in a bar chart, while a manipulated logarithmic scale can either flatten or amplify trends in a line chart. The fundamental grammar of charts, I learned, is the concept of visual encoding. These specifications represent the precise engineering that makes your Aeris Endeavour a capable, efficient, and enjoyable vehicle to own and drive. The chart is a quiet and ubiquitous object, so deeply woven into the fabric of our modern lives that it has become almost invisible. 59 This specific type of printable chart features a list of project tasks on its vertical axis and a timeline on the horizontal axis, using bars to represent the duration of each task. And Spotify's "Discover Weekly" playlist is perhaps the purest and most successful example of the personalized catalog, a weekly gift from the algorithm that has an almost supernatural ability to introduce you to new music you will love. This system, this unwritten but universally understood template, was what allowed them to produce hundreds of pages of dense, complex information with such remarkable consistency, year after year. 22 This shared visual reference provided by the chart facilitates collaborative problem-solving, allowing teams to pinpoint areas of inefficiency and collectively design a more streamlined future-state process. Ultimately, the chart remains one of the most vital tools in our cognitive arsenal. After design, the image must be saved in a format that preserves its quality. That simple number, then, is not so simple at all. 20 This small "win" provides a satisfying burst of dopamine, which biochemically reinforces the behavior, making you more likely to complete the next task to experience that rewarding feeling again. In the realm of education, the printable chart is an indispensable ally for both students and teachers. This is the semiotics of the material world, a constant stream of non-verbal cues that we interpret, mostly subconsciously, every moment of our lives. But when I started applying my own system to mockups of a website and a brochure, the magic became apparent. 11 More profoundly, the act of writing triggers the encoding process, whereby the brain analyzes information and assigns it a higher level of importance, making it more likely to be stored in long-term memory. It invites participation. It is the pattern that precedes the pattern, the structure that gives shape to substance. 20 This small "win" provides a satisfying burst of dopamine, which biochemically reinforces the behavior, making you more likely to complete the next task to experience that rewarding feeling again. 43 Such a chart allows for the detailed tracking of strength training variables like specific exercises, weight lifted, and the number of sets and reps performed, as well as cardiovascular metrics like the type of activity, its duration, distance covered, and perceived intensity. It is best to use simple, consistent, and legible fonts, ensuring that text and numbers are large enough to be read comfortably from a typical viewing distance. Presentation templates help in crafting compelling pitches and reports, ensuring that all visual materials are on-brand and polished. 46 By mapping out meals for the week, one can create a targeted grocery list, ensure a balanced intake of nutrients, and eliminate the daily stress of deciding what to cook. Once you have designed your chart, the final step is to print it. The first of these is "external storage," where the printable chart itself becomes a tangible, physical reminder of our intentions. 13 This mechanism effectively "gamifies" progress, creating a series of small, rewarding wins that reinforce desired behaviors, whether it's a child completing tasks on a chore chart or an executive tracking milestones on a project chart. Why this grid structure? Because it creates a clear visual hierarchy that guides the user's eye to the call-to-action, which is the primary business goal of the page. A printable is more than just a file; it is a promise of transformation, a digital entity imbued with the specific potential to become a physical object through the act of printing. They now have to communicate that story to an audience. A printable chart can effectively "gamify" progress by creating a system of small, consistent rewards that trigger these dopamine releases. While the methods of creating and sharing a printable will continue to evolve, the fundamental human desire for a tangible, controllable, and useful physical artifact will remain. These include everything from daily planners and budget trackers to children’s educational worksheets and coloring pages. Finally, the creation of any professional chart must be governed by a strong ethical imperative. Rule of Thirds: Divide your drawing into a 3x3 grid. The question is always: what is the nature of the data, and what is the story I am trying to tell? If I want to show the hierarchical structure of a company's budget, breaking down spending from large departments into smaller and smaller line items, a simple bar chart is useless. The construction of a meaningful comparison chart is a craft that extends beyond mere data entry; it is an exercise in both art and ethics. Most of them are unusable, but occasionally there's a spark, a strange composition or an unusual color combination that I would never have thought of on my own. 64 The very "disadvantage" of a paper chart—its lack of digital connectivity—becomes its greatest strength in fostering a focused state of mind. I started reading outside of my comfort zone—history, psychology, science fiction, poetry—realizing that every new piece of information, every new perspective, was another potential "old thing" that could be connected to something else later on. 21 The primary strategic value of this chart lies in its ability to make complex workflows transparent and analyzable, revealing bottlenecks, redundancies, and non-value-added steps that are often obscured in text-based descriptions. The printable chart is not a monolithic, one-size-fits-all solution but rather a flexible framework for externalizing and structuring thought, which morphs to meet the primary psychological challenge of its user. It cannot exist in a vacuum of abstract principles or aesthetic theories. There is often very little text—perhaps just the product name and the price. 59 These tools typically provide a wide range of pre-designed templates for everything from pie charts and bar graphs to organizational charts and project timelines. A designer using this template didn't have to re-invent the typographic system for every page; they could simply apply the appropriate style, ensuring consistency and saving an enormous amount of time. This makes it a low-risk business model. It is the difficult, necessary, and ongoing work of being a conscious and responsible citizen in a world where the true costs are so often, and so deliberately, hidden from view.Laboratory Products Microbiology Catalog
Brochures of microbiology products and services
Cover Journal of Basic Microbiology. 7/2017 2017 Journal of Basic
Corrigendum 2017 Journal of Applied Microbiology Wiley Online Library
Fish intestinal microbiome diversity and symbiosis unravelled by
Issue Information Cover 2017 Microbiology and Immunology Wiley
TMS Microbiology Catalogue Team Medical & Scientific Sdn Bhd
Test Bank Microbiology Practical Applications and Infection
Cover Journal of Basic Microbiology. 9/2017 2017 Journal of Basic
VBD Publications
IMMUNOLOGY AND MICROBIOLOGY VOL 1 (HB 2016)
Pharmaceutical Microbiology USA 2017 PDF
Catalog a4 microbiology and viruses 3d Royalty Free Vector
Molecular Microbiology Microbiology Journal Wiley Online Library
Cover Journal of Basic Microbiology. 6/2017 2017 Journal of Basic
Fundamentals of Microbiology BIOWEB® Colombia
Pharmaceutical Microbiology USA 2017 PDF
Pharmaceutical Microbiology USA 2017 PDF
Microbiology
Position and Molecular Chronology of a Colonial Green
2025 EU Microbiology Catalog EN PDF Beta Lactamase Antibiotics
Cover Journal of Basic Microbiology. 9/2016 2016 Journal of Basic
Catalog a4 microbiology and viruses 3d Royalty Free Vector
Microbiology Product Catalog EU en PDF Elisa Antibiotics
Essentials of Microbiology for Nurses, 1st Edition 2016 By Kannan
Water Microbiology Product Catalog PDF Water Chemistry
Catalog A4 Microbiology and Viruses. 3d Microscopic Stock Vector
UF... UF Microbiology and Cell Science & ASM Gators
Clinical microbiology 2016brochure PDF
20162017 Virtual Event Schedule LabRoots 2016 PDF
TESTBANKMICROBIOLOGY WITH DISEASE BY BODY SYSTEMS 5TH EDITION (BAUMAN
Microbiology Product Catalog 2020 2021 PDF Laboratory Techniques
(PDF) 2017 Immunology and Microbiology Catalog DOKUMEN.TIPS
Microbiology Lab Solutions Macmillan Learning CA
Cengage Learning
Related Post: